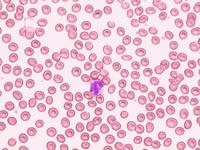
先天性紅細胞生成異常性貧血
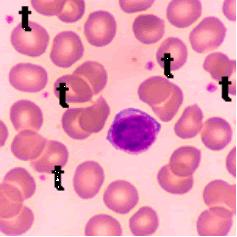
先天性紅細胞生成異常性貧血

概述
紅細胞
紅細胞1951年,Wolf等首次報導一家族中母子3人同患“難治性貧血”且骨髓中有核紅細胞呈多核、核碎裂和巨幼樣改變。
1962年 Bergstrom等報導一家族中15例貧血患者,骨髓紅系明顯增生,有核紅細胞巨幼樣改變、多核、核碎裂易見,葉酸、維生素B12 鐵劑治療無效,靠輸血維持,有遺傳傾向,作者命名為遺傳性良性網織紅細胞增生性貧血。
1966年,Crookston等將此類貧血正式命名為CDA。1968年 Heimpel等根據血細胞骨髓形態和血清學檢查,把CDA分為Ⅰ Ⅱ、Ⅲ 3型,之後,陸續有不同型CDA的報導。
流行病學
 先天性紅細胞生成異常性貧血
先天性紅細胞生成異常性貧血病因:
大部分學者認為CDA Ⅰ型、Ⅱ型為常染色體隱性遺傳,Ⅲ型為常染色體顯性遺傳。
發病機制:
發病機制至今不清楚。體外研究提示:各型CDA的造血異常主要在紅細胞系本身,造血微環境及粒系、巨核系細胞無明顯異常;形態上正常或無明顯異常的紅細胞與形態上明顯異常的紅細胞均來自同一克隆;核碎裂、多核可能與核蛋白合成異常、核膜異常或缺乏、核孔增寬、胞質和核內物質分布紊亂有關。
臨床表現
1.CDAⅠ型 至今已報導30多例患者。兄弟姐妹可同時或相繼發病,但未發現上下二代在同一家族發病。發病可在出生後(出現新生兒黃疸)、幼兒期,但多數至成人發病。查體可見脾大和黃疸,貧血為輕度。
2.CDA Ⅱ型 1969年Crookston又把此型命名為伴酸化血清試驗陽性的遺傳性原始紅細胞多核症(hereditary erythroblast multinuclearity with positive acidified serum test,HEMPAS) 此型相對常見,現已報導55個家族84例患者。臨床主要表現為正細胞性貧血、黃疸、肝脾腫大。貧血的程度因人而異 輕型患者(60%)幼年發病,血紅蛋白可達110g/L,早期無貧血症狀 到成年後才有貧血表現 約25%的患者病情相對較重,嬰幼兒期就需定期輸血維持。部分患者有特殊面容,顱骨雙層板增寬。
3.CDA Ⅲ型 此型最早被報導,1951年Wolf等所描述的病例即屬此型。現已報導4個家系23例患者。同一家系同代,不同代均可發病,提示為常染色體顯性遺傳。臨床上表現為中~輕度正色素性貧血,常用促造血藥物治療無效,但一般病情穩定,且預後良好。查體可見黃疸,無肝、脾 淋巴結腫大。
除上述三型外,20世紀70年代以來,又有人報導了界於Ⅰ、Ⅱ型之間的CDA,還有人報導了所謂CDA Ⅳ型,其主要特點是:骨髓形態類似於CDAⅡ型,但“i”抗原正常。
病理表現
血小板病理圖
血小板病理圖(一)先天性純紅再障(diamond-blackfan貧血)90%於初生到1歲內起病,罕有2歲以後發病者,遺傳規律尚不清,有家族性。患兒生長發育遲緩,少數也有輕度先天性畸形,如拇指畸形,和Fanconi貧血不同很少伴發惡性疾病。患者紅系祖細胞不但數量缺乏,並且質有異常。HbF增多,胎兒膜抗原i持續存在,嘌呤解救途徑酶活性增高,說明核酸合成有缺陷。患者淋巴細胞在體外可抑制正常紅系祖細胞的生長。20%病例可自發緩解,60%患者對腎上腺皮質激素有效,無效者亦可做骨髓移植。
(二)急性獲得性純紅再障在慢性溶血性貧血的病程中發生病毒感染,特別是人類微小病毒(parvovirus)B19感染,可選擇性抑制紅系祖細胞,發生急性純紅再障,又稱溶血性貧血的再生障礙性危象;某些病例在病毒感染後發生造血
 先天性紅細胞生成異常性貧血病理圖
先天性紅細胞生成異常性貧血病理圖功能暫時停頓,導致全血細胞減少,骨髓中出現巨原紅細胞,又稱急性造血停滯。急性純紅再障也可發生在1~4歲小兒,數周后自愈,並無感染因素,稱兒童暫時性幼紅細胞減少症。急性純紅再障尚見於病毒性肝炎和某些藥物誘發,如苯妥因、硫唑嘌呤、氯黴素、異煙肼和普魯卡因胺等,停藥後大多數病例會完全恢復。
(三)慢性獲得性純紅再障主要見於成人。50%患者伴有胸腺瘤,僅5%胸腺瘤患者有純紅再障;這些胸腺瘤多數系良性,70%為紡錘細胞型,少數為惡性;女性多見(女∶男為3~4.5∶1)。少數尚可繼發於某些自身免疫性疾病如系統性紅斑狼瘡和類風濕關節炎,及某些腫瘤如慢性淋巴細胞白血病、慢性粒細胞白血病、淋巴瘤、免疫母細胞淋巴結病、膽道腺癌、甲狀腺癌、支氣管肺癌及乳腺癌等。原因不明者稱原發性獲得性純紅再障,系多種免疫機制引起幼紅細胞生成抑制,患者血清中存在抗幼紅細胞抗體,抗紅細胞生成素抗體或具有抑制性T淋巴細胞等。患者常伴多種免疫學異常如免疫球蛋白增高或降低、單株免疫球蛋白及血清多種抗體陽性,如冷凝集素、冷溶血素、嗜異抗體、抗核抗體等。抗人球蛋白試驗等陽性。個別患者可伴多種內分泌腺功能減低。不伴胸腺瘤的純紅再障多見於男性(男∶女為2∶1)。
診斷
 先天性紅細胞生成異常性貧血病理圖
先天性紅細胞生成異常性貧血病理圖鑑別診斷:
1.CDA應與地中海貧血鑑別 因兩者都有家族性,都有單純貧血、黃疸及珠蛋白肽鏈的異常。但地中海貧血患者可有所謂“地貧面容”、網織紅細胞增高,紅細胞壽命明顯縮短、切脾治療效果佳等特點;而CDA可有染色質“橋”、紅細胞“鬼影”、巨大/多核紅細胞以及HEMPAS抗原和i抗原的改變等,藉此可區分兩種疾病 當然,如果將來對典型CDA患者做紅細胞基因檢查,無疑將更有助於鑑別之。
2.CDAⅡ型應與不發作型陣發性睡眠性血紅蛋白症(PNH)鑑別 因兩者都可出現酸溶血試驗陽性,但PNH紅細胞對補體敏感的機制與CDA截然不同:PNH是由於磷脂醯肌醇糖苷A類(PIG-A)基因異常導致血細胞膜上磷脂醯肌醇(GPI)錨接蛋白量少,進而影響補體調節;而CDA卻是由於HEMPAS抗原。故可通過測定紅細胞膜上的補體調節蛋白(DAF、CD59)鑑別之。另外,PNH病在造血幹細胞,特別是不發作型,往往表現為全血細胞減少和骨髓增生不良,藉此也可與CDAⅡ型相區別。
3.CDA與巨幼細胞貧血的鑑別 主要靠病史(包括營養史和家族史)和葉酸或(和)維生素B12的治療反應。CDA與骨髓增生異常綜合徵和白血病的鑑別主要依據後兩者為惡性病,往往累及全髓(全血細胞),且有病理、組化、染色體甚至癌基因的異常等。
實驗室檢查:
1.CDAⅠ型
(1)外周血:細胞大小不均 異形、點彩、卡波環均很明顯,白細胞和血小板均正常。
(2)骨髓象:紅系明顯增生,可見雙核紅細胞,多核紅細胞及巨大紅細胞,特徵性改變為Feulgen試驗陽性的連線兩個有核紅細胞的核間染色質橋。在電鏡下 染色質呈海綿狀,密度不均勻,胞核呈“乾酪”樣改變。
(3)血清間接膽紅素可增高:尿膽原增高。
(4)血清鐵增高或正常:紅細胞珠蛋白α與非α肽鏈比值增高,可見包涵小體,其他特異性溶血性貧血的病因學檢查皆陰性。
2.CDAⅡ型
(1)外周血:同樣可見紅細胞大小不均、異形紅細胞、點彩紅細胞,一位相顯微鏡下,可見紅細胞特徵性改變,即紅細胞“鬼影”;電鏡下觀察“鬼影”區域由雙層膜組成。
(2)骨髓象:增生明顯活躍,雙核紅細胞占紅系10%~40% 多為幼紅;與Ⅰ型不同的是很少見巨大紅細胞,有些患者可見網狀細胞吞噬紅細胞現象。
(3)成熟紅細胞出現PNH紅細胞樣改變:對酸化血清敏感,已證明這是因為CDAⅡ型紅細胞膜表面存在HEMPAS抗原,抗原-抗體反應激活經典補體途徑所致。但其對酸化血清的敏感性比PNH差,蔗糖試驗從不發生溶血。進一步的研究還表明,HEMPAS抗原是由N-乙醯葡萄糖胺轉移酶Ⅱ遺傳異常所致,因為此酶的異常導致組成細胞膜糖蛋白糖類部分異常,特別是帶3、帶4 5,可能還有糖蛋白A的異常。另外一血清學異常是紅細胞表面“i”抗原增加。
3.CDA Ⅲ型
(1)外周血:成熟紅細胞明顯大小不均,可見巨大紅細胞 有核紅細胞,網織紅細胞計數正常或偏低,白細胞及血小板正常。
(2)骨髓象:紅系明顯增生,各階段有核紅細胞均可見巨大改變,部分有核紅細胞胞體直徑達50~60μm,含有10~12個核仁,二核 三核、多核紅細胞、核碎裂很常見,粒系、巨核系細胞形態大致正常。
(3)血清鐵水平升高:血清間接膽紅素增高,尿膽原增高。
(4)紅細胞珠蛋白β肽鏈增多:可見包涵體,紅細胞壽命、鹽水滲透脆性試驗、酸化血清溶血試驗、Coombs試驗皆正常。
其它輔助檢查:
根據病情選擇B超、心電圖、X線等檢查。
治療及預後
治療:
鐵劑、葉酸、維生素B12及脾切除等對CDA均無明顯療效,輸濃縮紅細胞是惟一的糾正貧血療法。併發症主要為輸血引起的血色病或切脾後繼發感染。
預後:
先天性紅細胞生成異常性貧血預後好。
